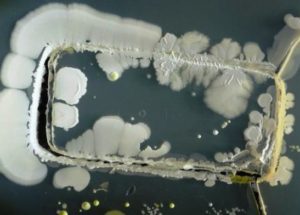
Smartphones Are The Filthiest Objects We Use On A Daily Basis

Obese Parents Are More Likely To Pass On Obesity To Their Children
The annual report conducted by NHS Digital in the UK revealed that children of obese parents are more likely to suffer from obesity in comparison with those with of parents with a healthy weight. It seems that this trend is due…